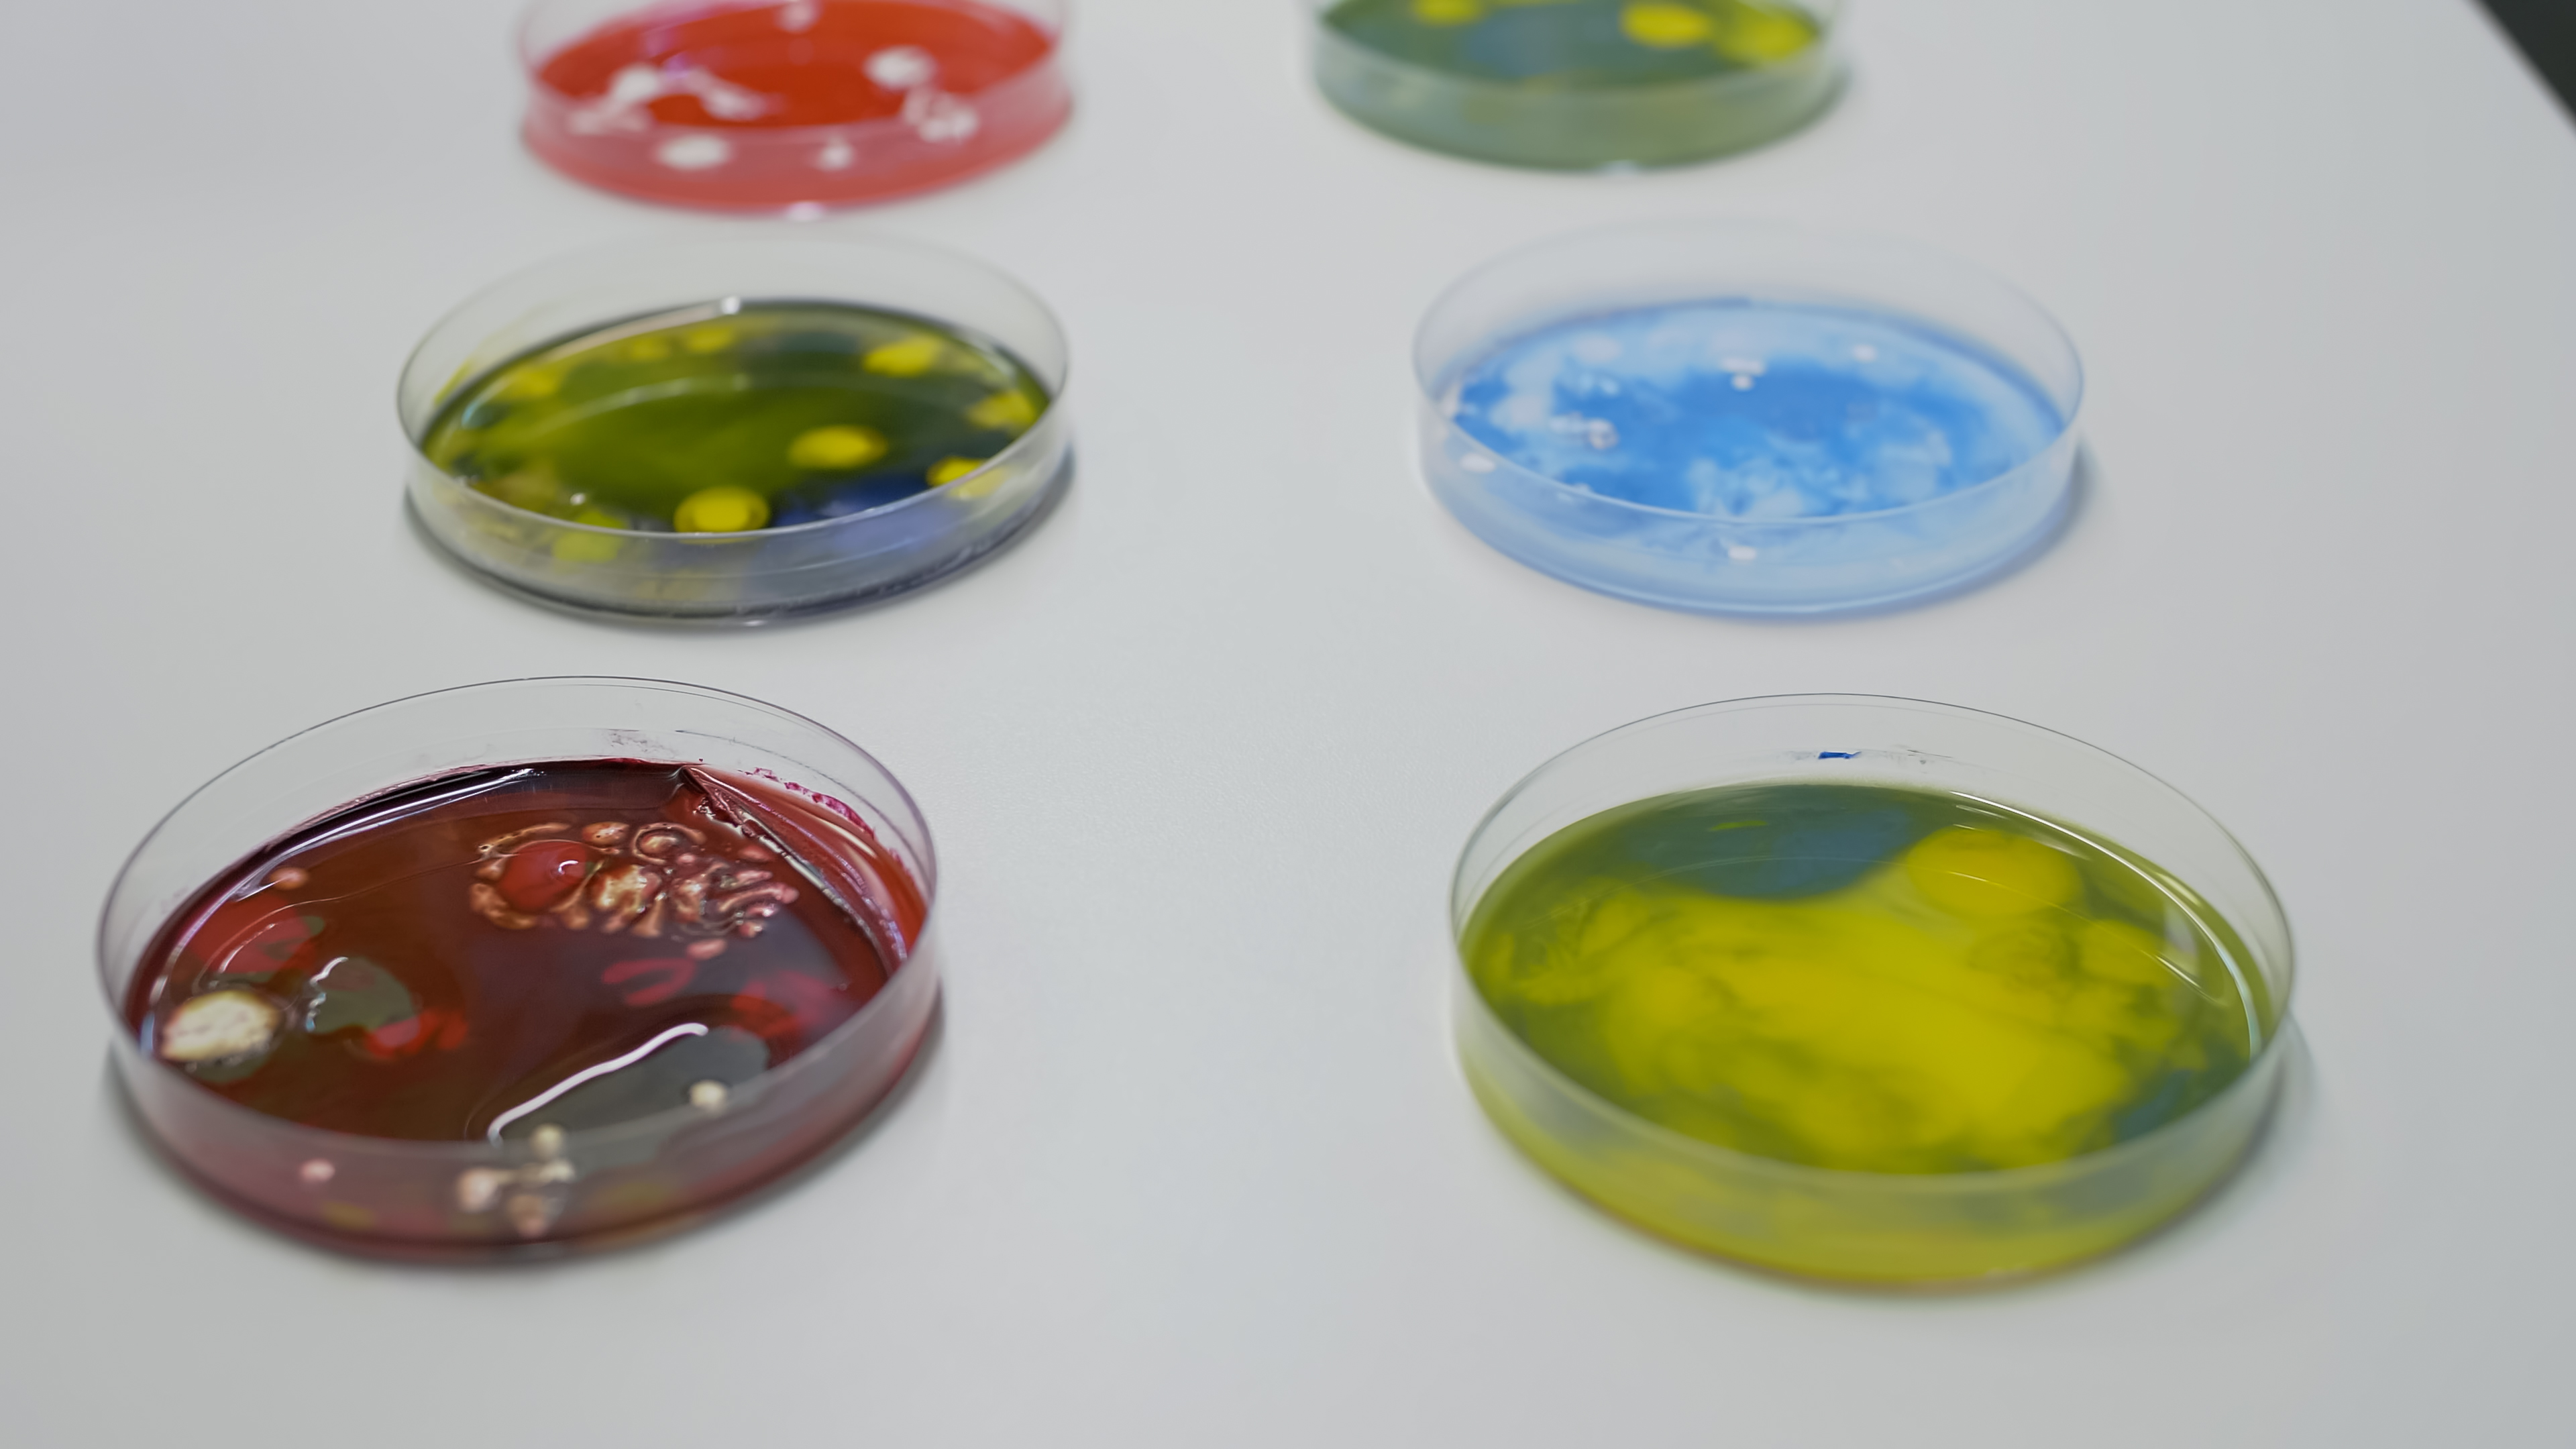
Mobirise

Schlafplatz finden.
Ein krankes Bett raubt Ihnen Nacht für Nacht Kraft und Gesundheit. Finden Sie heute Ihren
Schlafplatz, der Körper und Geist nachhaltig belebt.
Gesundes Leben startet mit dem richtigen Schlaf. Wählen Sie einen Schlafplatz, der Ihre
Selbstregulation unterstützt und Sie jeden Tag gestärkt erwachen lässt.
Träumen Sie von frischem Erwachen und voller Energie? Beginnen Sie mit einem Bett, das Ihnen
Schutz und Komfort schenkt. Finden Sie jetzt Ihren perfekten Schlafplatz.